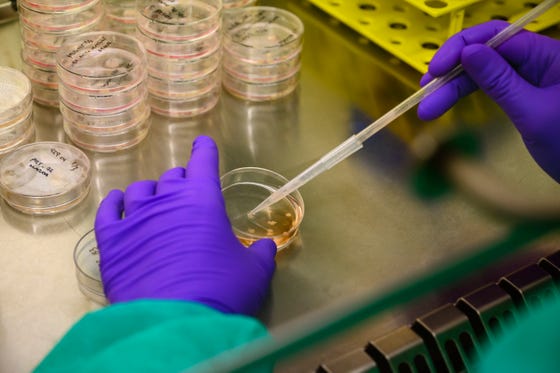

Terug
Services
UPORT supports the acquisition of healthy and diseased patient tissues and associated clinical data for your organoid research project.
UPORT activities
- Writing patient inclusion protocols and submit those for ethical evaluation by the TcBio
- Selecting patients based on the inclusion and exclusion criteria
- Patient inclusion by conducting inclusion interviews and obtaining informed consent
- Arrange and manage the logistical pathways to obtain the material and clinical data
- Collection of associated clinical patient data
- Maintaining a catalogue of living biobanks for researchers

Education
UPORT can facilitate an organoid cell culture training, which will teach you all the basics you need to apply organoid technology in your own lab. The location of the training will be at the Laboratory of Translational Oncology (LTO).
*Additional requests for help can always be discussed